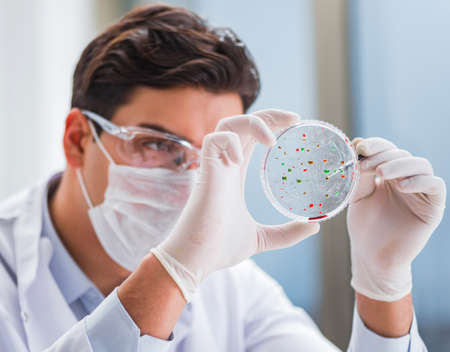
Male doctor working in the lab on virus vaccineの写真素材

写真素材 - Male doctor working in the lab on virus vaccine
キーワード
- analysis
- analyzing
- bacteria
- biochemistry
- biological
- biology
- biotechnology
- blood
- cancer
- care
- cell
- chemical
- chemist
- chemistry
- clinic
- clinical
- disease
- dna
- doctor
- education
- equipment
- experiment
- forensic
- health
- healthcare
- hematology
- hospital
- infection
- lab
- laboratory
- medical
- medicine
- microbiology
- microscope
- pharmaceutical
- pharmacy
- plasma
- professional
- research
- researcher
- sample
- science
- scientific
- scientist
- technician
- technology
- test
- tube
- virus
類似作品
Where medical s...
Online Medical ...
An adult male C...
Biologist's exc...
asian male doct...
Exhausted stres...
Sterile laborat...
Scientist worki...
A young scienti...
Female doctor h...
Doctor analyzin...
Surgeon perform...
Two doctors and...
Technician repa...
Young male scie...
Contemporary sc...
A researcher is...
young doctor sc...
Focused scienti...
Portrait of a ...
Scientist adjus...
In the clinic, ...
Doctor in blue ...
Chemist is chem...
Medical profess...
Scientist worki...
At the hospital...
Young male chem...
Scientist in la...
Portrait of a b...
Blurred of red ...
Scientist in la...
A scientist in ...
Doctors are mee...
Young male chem...
Young male chem...
A scientist in ...
Young male chem...
A scientist is ...
A focused male ...
Healthcare prof...
Male Scientist ...
Two doctors and...
Scientist worki...
Young doctor in...
Male student of...
Bacteria growth...
Portrait of han...
healthy concept...